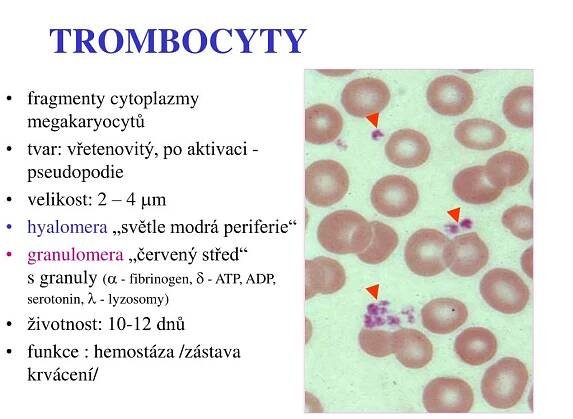

Krevní destičky (trombocyty) jsou "útržky" buněk – megakaryocytů. Mají na starosti srážení krve a udržení cév bez trhlin. Jejich normální koncentrace se pohybuje kolem 200 až 400 miliard v litru krve.
Krevní destička – Wikipedie
Trombocyty jsou schopny specificky vázat imunoglobulin G (IgG) přes Fcyriia, receptor pro konstantní fragment (Fc) IgG. Po aktivaci trombocytu a vazbě na opsonizovanou bakterii pomocí IgG krevní destičky následně uvolňují reaktivní druhy…
Krevní destičky neboli trombocyty - jak zajistit správnou…
Co jíst, aby se zvýšil počet krevních destiček? Jak zvýšit nízkou hladinu krevních destiček? To a další informace naleznete v tomto článku.
trombocyty | NZIP
Trombocyty neboli krevní destičky jsou součástí krve. Krevní destičky společně s bílými krvinkami tvoří méně než 1 % objemu krve. Trombocyty hrají nezastupitelnou ...
Trombocyt | Medicína, nemoci, studium na 1. LF UK
Trombocyty (krevní destičky) jsou bezjaderné krevní elementy, které hrají roli ve srážení krve. V krvi se jich nachází asi 150-350 x 109 na litr. Běžná délka života trombocytu je asi 9 dnů.
Trombocyty neboli krevní destičky: Jaké důležité funkce…
Zdravě.cz - zdravý životní styl, informace o nemocech a jejich léčbě, těhotenství a péče o dítě, hubnutí, alternativní medicína, sport a relaxace, vztahy a sex
odkazuje na služby nejen od Seznam.cz.
© 1996–2025 Seznam.cz, a.s.